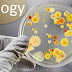

biology - Duke University in United State
Unknown
00:14
Majors and the Minor The Bachelor of Arts (B.A.) in science is the human sciences real program, fitting for understudies arranging a profes...
biology - Duke University in United State
Reviewed by Unknown
on
00:14
Rating: